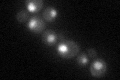
YDR138W
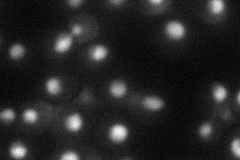
YDR138W
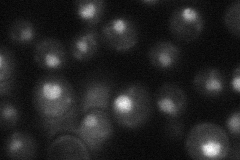
YDR138W
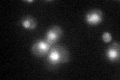
YDR138W

View description
Subunit of THO/TREX complexes that couple transcription elongation with mitotic recombination and with mRNA metabolism and export, subunit of an RNA Pol II complex; regulates lifespan; involved in telomere maintenance; similar to Top1p
Localization:
Intensity:
Fold change:
Significance:
-
C’ GFP library in SD
nucleus34.95 -
N' NOP1pr-GFP in SD

nucleus50.4539 -
N' TEF2pr-mCherry in SD
nucleus26.9435 -
N' NATIVEpr-GFP in SD
nucleus27.8483 -
N' TEF2pr-VC and Cyto-VN in SD

nucleus30.8394 -
C’ GFP library in SD+DTT

nucleus36.911.05No -
C’ GFP library in SD+H2O2
nucleus38.231.09No -
C’ GFP library in Starvation Media

nucleus28.980.82No -
C’ GFP library on the background of Pup2-DaMP

nucleus -
C’ GFP library on the background of CCT mutant

nucleus37.45941.07159No
